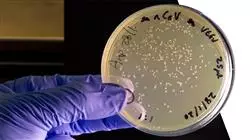
prasenztudium klinische infektiologie antibiotikatherapie Tech Universidad

Universitäre Qualifikation
Mit dieser praktischen Ausbildung machen Sie den endgültigen Schritt in Ihrer Karriere.”
Präsentation
Die Praktische ausbildung in Klinische Infektiologie und Antibiotikatherapie versetzt Sie in die Lage, antimikrobielle Behandlungsverfahren bei Patienten mit Nieren- oder Leberinsuffizienz zu beherrschen“

Eine der Hauptsorgen der Forscher auf dem Gebiet der Infektionskrankheiten sind die neu auftretenden Viren tierischen Ursprungs, da die Befürchtung groß ist, dass Antibiotika gegen bestimmte Krankheiten nicht wirksam sind und die Entwicklung neuer Krankheitserreger verursachen könnten. Antibiotika sind gegen bestimmte Krankheiten unwirksam und könnten sich auf Millionen von Menschen ausbreiten. Aus diesem Grund werden ständig neue Medikamente entwickelt, um neu auftretende Krankheiten zu bekämpfen, aber auch solche, die schon lange in der Gesellschaft vorhanden sind, mit dem Ziel, sie auszurotten.
Angesichts dieser Situation hat TECH diese Praktische ausbildung entwickelt, die es den Studenten ermöglichen soll, den Einsatz der neuesten Antibiotika zur Bekämpfung verschiedener Infektionskrankheiten zu beherrschen. Dies geschieht auf 100% praktische Weise durch eine 120-stündige Erfahrung im Krankenhaus mit den besten Spezialisten auf diesem Gebiet. Während dieser Zeit lernt der Arzt die Protokolle für die Behandlung mit antimikrobiellen Mitteln bei schwangeren oder niereninsuffizienten Patienten sowie die Verabreichung von Virostatika bei verschiedenen Krankheiten.
Um sicherzustellen, dass der Unterricht den Erwartungen der Studenten entspricht, werden sie jederzeit von einem bestimmten Tutor betreut, der sie dazu anhält, sich eine Reihe von Fähigkeiten anzueignen, die sie zu führenden Fachkräften auf dem Gebiet der Infektionskrankheiten machen werden.

Die von diesen Fachleuten ausgearbeiteten didaktischen Materialien dieses Studiengangs haben vollständig auf Ihre Berufserfahrung anwendbare Inhalte"
Unterrichtsplanung
Diese Praktische ausbildung soll durch einen dreiwöchigen Aufenthalt in einem renommierten Krankenhaus von Montag bis Freitag mit aufeinanderfolgenden 8-stündigen Arbeitstagen unter der Leitung eines Facharztes auf diesem Gebiet absolviert werden. In dieser praktischen Phase werden die Studenten ihre Aufgaben an echten Patienten ausführen und sich als Teil eines multidisziplinären Teams die neuesten Kenntnisse für die Diagnose und Behandlung verschiedener Infektionskrankheiten aneignen.

In diesem ganz auf die Praxis ausgerichteten Fortbildungsangebot zielen die Aktivitäten auf die Entwicklung und Vervollkommnung der Kompetenzen ab, die für die Erbringung von Gesundheitsdienstleistungen in Bereichen und unter Bedingungen erforderlich sind, die ein hohes Maß an Qualifikation erfordern, und die auf eine spezifische Ausbildung für die Ausübung der Tätigkeit in einem Umfeld der Sicherheit für den Patienten und hoher professioneller Leistung ausgerichtet sind.
TECH bietet ihnen daher eine ausgezeichnete Gelegenheit, ihre Fähigkeiten durch die Arbeit in einem Krankenhaus mit modernster Technologie und bester Ausstattung weiterzuentwickeln, in dem die Optimierung der medizinischen Behandlung von entscheidender Bedeutung ist, um die Genesung und eine angemessene Lebensqualität der von verschiedenen Infektionskrankheiten betroffenen Patienten zu gewährleisten.
Der praktische Unterricht erfolgt in Begleitung und unter Anleitung der Dozenten und der übrigen Ausbildungskollegen, um Teamarbeit und multidisziplinäre Integration als übergreifende Kompetenzen für die medizinische Praxis zu fördern (Lernen, zu sein und lernen, mit anderen in Beziehung zu treten).
Die im Folgenden beschriebenen Verfahren werden die Grundlage der Ausbildung darstellen. Ihre Durchführung hängt von der Verfügbarkeit, der üblichen Tätigkeit und der Arbeitsbelastung des Zentrums ab:
Mikrobiologische Diagnose und andere Tests für Infektionskrankheiten
- Entnehmen der erforderlichen Proben für die Ausarbeitung der verschiedenen Tests zum Nachweis von Infektionskrankheiten
- Durchführen von Protokollen für virologische, bakteriologische, mykologische und parasitologische Untersuchungen zum Nachweis von Infektionskrankheiten
- Richtiges Interpretieren der Ergebnisse mikrobiologischer Untersuchungen zum Nachweis der Infektionskrankheit eines Patienten
Bakterielle Erkrankungen und antimikrobielle Mittel
- Effizientes Behandeln der verschiedenen bakteriellen Infektionen der Haut
- Diagnostizieren und Behandeln von Harnwegsinfektionen und gynäkologischen Infektionen bei Frauen
- Anwenden von Penicillin und Beta-Lactamase-Hemmern zur Bekämpfung verschiedener bakterieller Erkrankungen
Parasitäre, tropische und Pilzkrankheiten
- Anwenden der entsprechenden Behandlung für jede der häufigsten Pilzinfektionen
- Diagnostizieren und Behandeln von Malaria oder von Krankheiten, die durch Darmprotozoen verursacht werden
- Behandeln verschiedener parasitärer und tropischer Krankheiten unter Verwendung eines pharmakokinetischen und pharmakodynamischen Ansatzes
Antimikrobielle Resistenz und angemessene Verwendung von antimikrobiellen Mitteln
- Durchführen einer alternativen Behandlung für Patienten, die unzureichend auf antimikrobielle Mittel ansprechen
- Verabreichen von antimikrobiellen Mitteln an Patienten in besonderen Situationen wie Schwangere oder Menschen mit Nieren- oder Leberinsuffizienz
Bilden Sie sich an einer Institution aus, die Ihnen all diese Möglichkeiten bietet, mit einem innovativen akademischen Programm und einem Team, das Sie optimal fördern kann“
Praktische Ausbildung in Klinische Infektiologie und Antibiotikatherapie
Die TECH Technologische Universität stellt Ihnen unsere exklusive Praktische Ausbildung in Klinische Infektiologie und Antibiotikatherapie vor, die Ihnen die aktuellste Fortbildung im Gesundheitsbereich bieten soll. Wenn Sie als Mediziner Ihr Wissen erweitern und praktische Fähigkeiten in der Diagnose und Behandlung von Infektionskrankheiten erwerben möchten, ist dieses Programm ideal für Sie. Unsere Präsenzkurse, die von anerkannten Experten für Infektionskrankheiten abgehalten werden, bieten Ihnen die Möglichkeit, auf interaktive Weise zu lernen, Erfahrungen mit Fachleuten aus verschiedenen Spezialgebieten auszutauschen und die Vorteile der Anwesenheit vor Ort zu nutzen. Während des gesamten Programms haben Sie Zugang zu den neuesten wissenschaftlichen und technologischen Fortschritten auf diesem Gebiet sowie zu den besten Praktiken und Strategien, um den Herausforderungen der modernen Medizin zu begegnen.
Holen Sie sich ein professionelles Update in dem Wissenschaftszweig, der die Zukunft der Medizin sein wird
In diesem Programm konzentrieren wir uns auf die relevantesten und aktuellsten Inhalte, damit Sie diese sofort in Ihrer klinischen Praxis anwenden können. Wir werden uns eingehend mit Themen wie dem Management nosokomialer Infektionen, dem rationellen Einsatz antimikrobieller Mittel, der Interpretation diagnostischer Tests und Strategien zur Prävention und Kontrolle von Infektionskrankheiten befassen. Darüber hinaus lernen Sie die optimale Antibiotikatherapie für verschiedene Arten von Infektionen kennen, einschließlich solcher, die durch multiresistente Bakterien verursacht werden. Die TECH Technologische Universität ist stolz darauf, Ihnen alle Werkzeuge für eine gute medizinische Praxis an die Hand zu geben, die auf akademischer Exzellenz und ständiger Fortbildung unserer Fachleute beruht. Unsere Praktische Ausbildung in Klinische Infektiologie und Antibiotikatherapie vermittelt Ihnen die fortgeschrittenen Fähigkeiten, die Sie benötigen, um ein hochqualifizierter Spezialist zu werden, der bereit ist, sich den Herausforderungen der heutigen medizinischen Welt zu stellen. Verpassen Sie nicht die Gelegenheit, Ihre Karriere voranzutreiben und etwas für die Gesundheit Ihrer Patienten zu tun.







